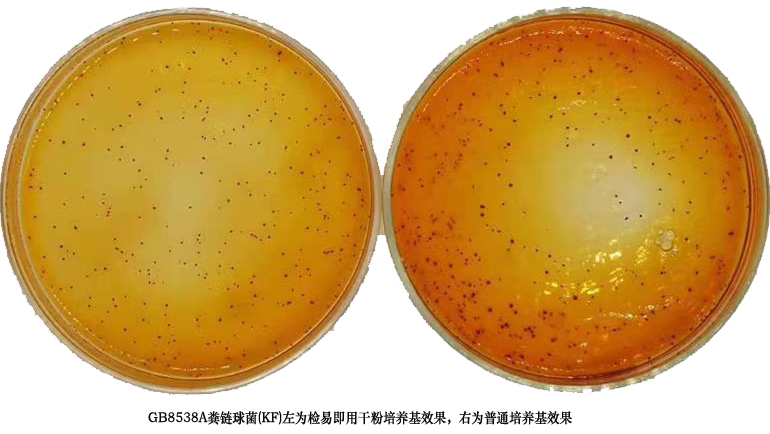
KF(粪链球菌)KM1-GB8538A

库号:M208229
红色菌落即为粪链球菌。
无需额外添加TTC,现用现水化。
48小时即可计数结果
适于水质卫生、等检测
5袋/包
粪链球菌(KF)即用型干粉培养基说明书
一、原理
培养基含有营养成分、选择性抑菌剂、指示剂和冷水可溶性凝胶。营养成分提供粪链球菌生长所需营养;选择性
抑制剂可抑制其它细菌的生长;当有菌落形成,指示剂显红色;冷水可溶性凝胶替代琼脂起凝固剂作用。培
养基经射线灭菌,可直接使用不必加热灭菌。
二、包装规格
5袋/包。
三、检验方法
1.检验
①水质检验
将干粉倒入无菌培养皿中,沿桌面轻轻摇匀,使干粉平铺于皿底,同时避免干粉接触平皿边缘(边角处干粉不易
水化),取10mL无菌生理盐水倒入平皿中,沿桌面混匀,静置20min使凝胶完全凝固。将250mL水样过滤,取
下滤膜,有菌面朝上贴于KF平板上。
②样品检测
将干粉倒入无菌培养皿中,沿桌面轻轻摇匀,使干粉平铺于皿底,同时避免干粉接触平皿边缘(边角处干粉不易
水化)。吸取1mL适宜稀释度的样液加入到9mL无菌生理盐水中,混匀全部倒入平皿中,沿桌面混匀,静置20min,
使凝胶完全凝固。
2.培养
培养皿正放(平皿盖在上),36℃±1℃培养48h。
3.计数
红色、浅红色或暗红色菌落为粪链球菌。若需验证,请按GB 8538标准进行。废弃物需经121℃高压灭菌20分钟后
处理。
四、储存
避光阴凉处保存,保质期1年。
红色菌落即为粪链球菌。
无需额外添加TTC,现用现水化。
48小时即可计数结果
适于水质卫生、等检测
5袋/包
粪链球菌(KF)即用型干粉培养基说明书
一、原理
培养基含有营养成分、选择性抑菌剂、指示剂和冷水可溶性凝胶。营养成分提供粪链球菌生长所需营养;选择性
抑制剂可抑制其它细菌的生长;当有菌落形成,指示剂显红色;冷水可溶性凝胶替代琼脂起凝固剂作用。培
养基经射线灭菌,可直接使用不必加热灭菌。
二、包装规格
5袋/包。
三、检验方法
1.检验
①水质检验
将干粉倒入无菌培养皿中,沿桌面轻轻摇匀,使干粉平铺于皿底,同时避免干粉接触平皿边缘(边角处干粉不易
水化),取10mL无菌生理盐水倒入平皿中,沿桌面混匀,静置20min使凝胶完全凝固。将250mL水样过滤,取
下滤膜,有菌面朝上贴于KF平板上。
②样品检测
将干粉倒入无菌培养皿中,沿桌面轻轻摇匀,使干粉平铺于皿底,同时避免干粉接触平皿边缘(边角处干粉不易
水化)。吸取1mL适宜稀释度的样液加入到9mL无菌生理盐水中,混匀全部倒入平皿中,沿桌面混匀,静置20min,
使凝胶完全凝固。
2.培养
培养皿正放(平皿盖在上),36℃±1℃培养48h。
3.计数
红色、浅红色或暗红色菌落为粪链球菌。若需验证,请按GB 8538标准进行。废弃物需经121℃高压灭菌20分钟后
处理。
四、储存
避光阴凉处保存,保质期1年。